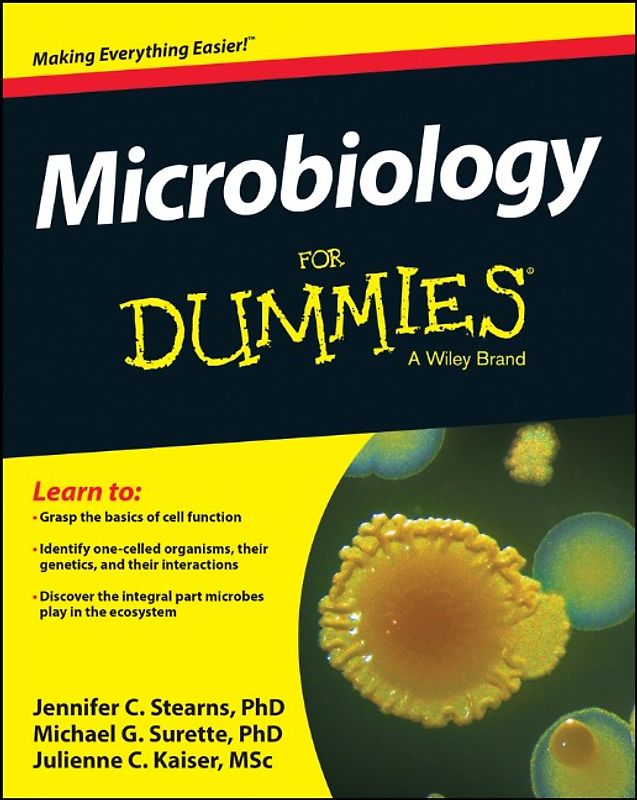
Microbiology For Dummies

iPhoneAlle anzeigen
iPhone 11iPhone 11 ProiPhone 11 Pro MaxiPhone 12iPhone 12 ProiPhone 12 Pro MaxiPhone 12 miniiPhone 13iPhone 13 ProiPhone 13 Pro MaxiPhone 13 miniiPhone 14iPhone 14 PlusiPhone 14 ProiPhone 14 Pro MaxiPhone 15iPhone 15 PlusiPhone 15 ProiPhone 15 Pro MaxiPhone 16iPhone 16 PlusiPhone 16 ProiPhone 16 Pro MaxiPhone 16eiPhone 8iPhone 8 PlusiPhone SE 2020iPhone SE 2022iPhone XiPhone XRiPhone XSiPhone XS Max
Galaxy A-SerieAlle anzeigen
Galaxy A12Galaxy A13Galaxy A13 5GGalaxy A14Galaxy A15Galaxy A16Galaxy A17 5GGalaxy A20eGalaxy A21Galaxy A22Galaxy A23Galaxy A24Galaxy A25Galaxy A26 5GGalaxy A32Galaxy A33Galaxy A34Galaxy A35Galaxy A36 5GGalaxy A40Galaxy A41Galaxy A42Galaxy A50Galaxy A51Galaxy A52Galaxy A53Galaxy A54Galaxy A55Galaxy A56 5GGalaxy A70Galaxy A71Galaxy A72
Redmi SeriesAlle anzeigen
Redmi 10Redmi 13CRedmi 15 5GRedmi Note 10Redmi Note 10 ProRedmi Note 11Redmi Note 11 ProRedmi Note 11 Pro Plus 5GRedmi Note 11sRedmi Note 12Redmi Note 12 5GRedmi Note 12 ProRedmi Note 12 Pro 5GRedmi Note 12 Pro PlusRedmi Note 13Redmi Note 13 5GRedmi Note 13 ProRedmi Note 13 Pro PlusRedmi Note 14Redmi Note 14 Pro PlusRedmi Note 8Redmi Note 8 ProRedmi Note 9Redmi Note 9 Pro
- Startseite
Bücher Englische Bücher Wissen & Bildung Naturwissenschaft, Medizin, Informatik, Technik Medizin Microbiology For Dummies
Derzeit nicht verfügbar
Handgeprüfte Gebrauchtware
Bis zu 50 % günstiger als neu
Der Umwelt zuliebe
Microbiology For Dummies
Jennifer Stearns (Taschenbuch, Englisch)
★★★★★
☆☆☆☆☆ Keine Bewertungen vorhanden
Optischer Zustand
Beschreibung
Microbiology is the study of life itself, down to the smallest particle
Microbiology is a fascinating field that explores life down to the tiniest level. Did you know that your body contains more bacteria cells than human cells? It's true. Microbes are essential to our everyday lives, from the food we eat to the very internal systems that keep us alive. These microbes include bacteria, algae,… fungi, viruses, and nematodes. Without microbes, life on Earth would not survive. It's amazing to think that all life is so dependent on these microscopic creatures, but their impact on our future is even more astonishing. Microbes are the tools that allow us to engineer hardier crops, create better medicines, and fuel our technology in sustainable ways. Microbes may just help us save the world.
Microbiology For Dummies is your guide to understanding the fundamentals of this enormously-encompassing field. Whether your career plans include microbiology or another science or health specialty, you need to understand life at the cellular level before you can understand anything on the macro scale.
* Explore the difference between prokaryotic and eukaryotic cells
* Understand the basics of cell function and metabolism
* Discover the differences between pathogenic and symbiotic relationships
* Study the mechanisms that keep different organisms active and alive
You need to know how cells work, how they get nutrients, and how they die. You need to know the effects different microbes have on different systems, and how certain microbes are integral to ecosystem health. Microbes are literally the foundation of all life, and they are everywhere. Microbiology For Dummies will help you understand them, appreciate them, and use them. Dieses Produkt haben wir gerade leider nicht auf Lager.
Handgeprüfte Gebrauchtware
Bis zu 50 % günstiger als neu
Der Umwelt zuliebe
Technische Daten
Erscheinungsdatum
01.01.2014
Sprache
Englisch
EAN
9781118871188
Herausgeber
John Wiley & Sons
Sonderedition
Nein
Autor
Jennifer Stearns
Seitenanzahl
384
Einbandart
Taschenbuch
Schlagwörter
Medical Science, Medizin, Microbiology, Mikrobiologie, Mikrobiologie u. Virologie
Thema-Inhalt
MKFM - Mikrobiologie und Virologie
Höhe
235 mm
Breite
18.8 cm
-.-
★★★★★
☆☆☆☆☆ Leider noch keine Bewertungen
Leider noch keine Bewertungen
Sicher bei rebuy kaufen
Schreib die erste Bewertung für dieses Produkt!
Wenn du eine Bewertung für dieses Produkt schreibst, hilfst du allen Kund:innen, die noch überlegen, ob sie das Produkt kaufen wollen. Vielen Dank, dass du mitmachst!
Sicher bei rebuy kaufen

